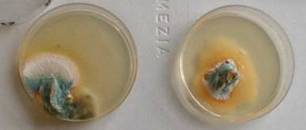
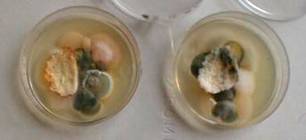

I bambini-scienziati della classe hanno osservato l'esistenza di molte muffe diverse, trasportate forse dalle cose che hanno appoggiato sulle piastre di "gelatina" incontaminata.
Questi i risultati:

Capelli (Federico e Riccardo) - Funghetti appassiti secchi (Asmba e Mattia) - Pane (Simone e Mattia)

Polvere (Martina e Leonardo) - Unghie varie (Matteo e Davide) - Sopracciglia (Matteo B. e Federica)
Le piastre contengono una gelatina nutriente (tecnicamente “terreno Sabourod agarizzato”) adatta alla crescita di tutte le muffe. Finché le piastre restano chiuse non si sviluppa in esse nessuna muffa né altro, così come dalla terra non cresce nulla se non si mette un seme o se un seme non si trova lì per caso. Quindi occorre mettere dentro qualcosa che possa contenere piccole spore, come quelle che si trovano sotto il cappello dei funghi.
Per questa esperienza basta aprire la piastra per il breve tempo sufficiente a inserire l’oggetto, richiuderla e lasciarla per qualche giorno in un luogo buio. Ogni cosa ha prodotto delle muffe, perciò si capisce che le muffe stanno un po’ dappertutto.
Constatata la crescita di una gran varietà di muffe, gli allievi hanno notato che ogni cosa aveva prodotto una muffa differente per aspetto, forma, colori. Perciò si sono chiesti se potesse esserci una relazione tra il tipo di muffa e l’oggetto che l’ha generata, cioè se ciascun oggetto fosse “contaminato” con un tipo preciso di muffa, oppure se la muffa si formasse casualmente.
Per rispondere a questa domanda ogni oggetto (per esempio la mollica di pane) è stato diviso e posto su due piastre uguali. Qui sotto i risultati.

Due metà di uno stesso spicchio di mela: le due muffe differiscono solo per l’estensione della zona grigia vellutata.
Due metà di uno stesso spicchio di mandarino: anche in questo caso si hanno le stesse colorazioni, ma con uno sviluppo molto diverso della peluria bianca.
Anche per la buccia di mandarino si ha una sostanziale corrispondenza nelle due piastre.
Si può concludere che le muffe sono nelle cose scelte per gli esperimenti.
Mentre si svolgeva l'esperimento gli allievi si sono accorti che nei barattoli delle pesche sciroppate che avevano mangiato c'era della muffa che galleggiava sul liquido. La maestra ha chiesto cosa fosse cambiato dal momento che avevano preparato le pesche a quello successivo all'aver aperto e richiuso il barattolo.
I bambini hanno risposto che era entrata l'aria e che le muffe potevano stare anche nell'aria. Allora i bambini hanno " raccolto" l'aria della classe per 5 minuti su una piastra e per altrettanti quella del giardino. E' risultato che l’aria del giardino contiene tanti tipi di muffe diverse, mentre l’aria della classe ne ha prodotto solo uno.
Questa ricerca sperimentale sulle muffe, che lascia aperte ancora varie domande, è stata utile alla nostra ricerca sulla conservazione degli alimenti, della quale si riporta una mappa concettuale.

Esperienza realizzata nel novembre 2004 dagli allievi della classe 4ªB del plesso Le Grazie, 2° Circolo di Recanati.